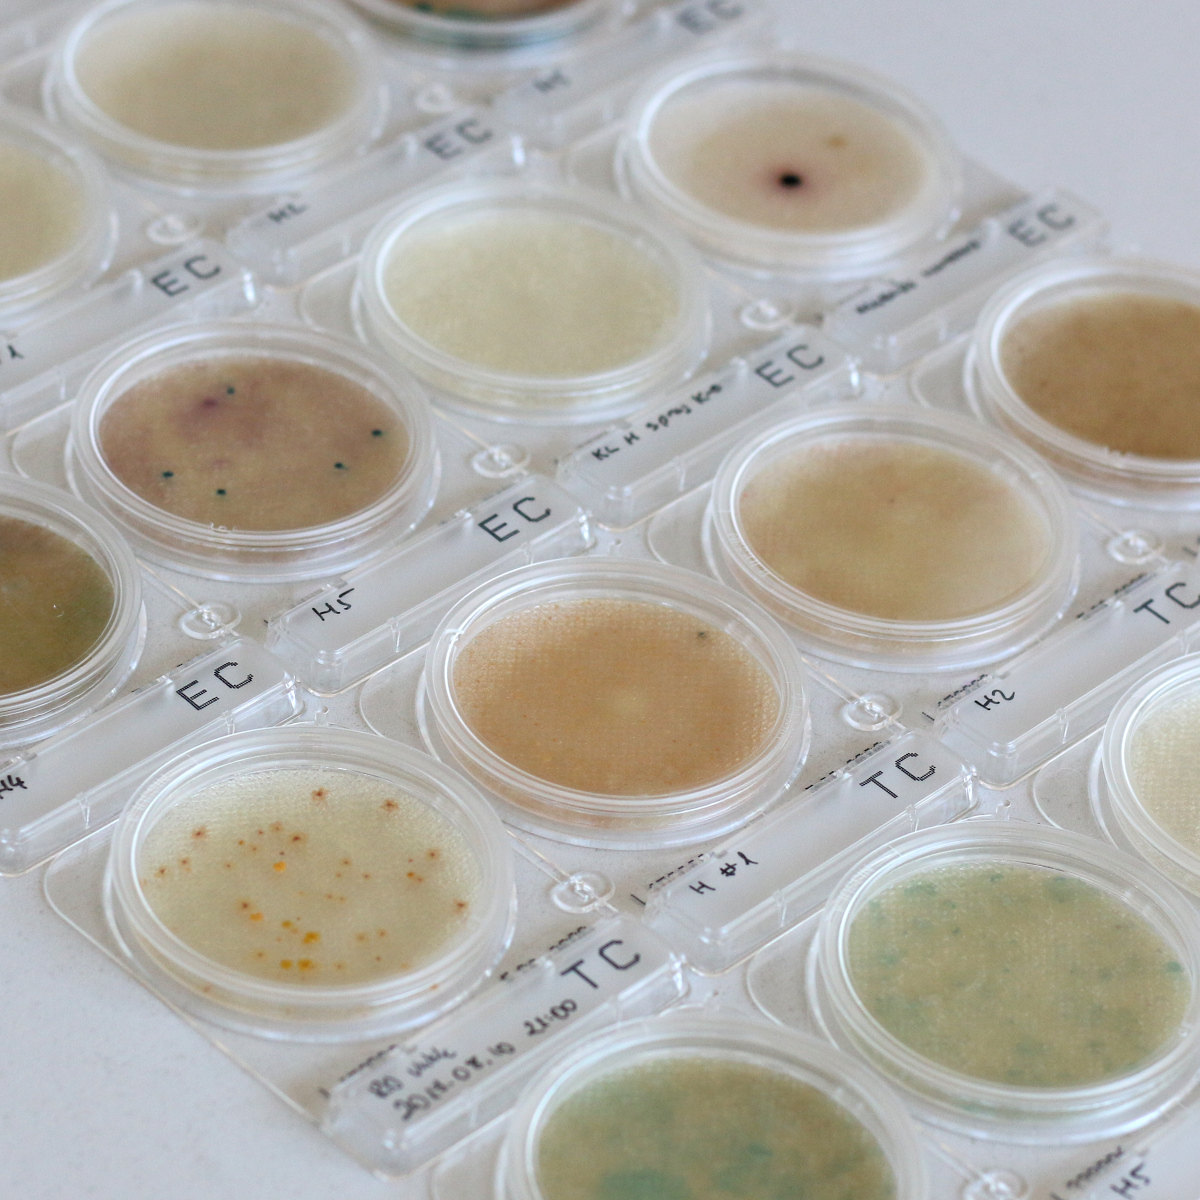

UltraGreen - Új magyar ökocímke, ami a csomagolást is figyelembe veszi!
A közelmúltban létrejött egy új, magyarországi fejlesztésű ökocímke. Ezzel a hazai kisvállalkozások számára egy új lehetőség nyílt, hogy megfizethető, ám mégis megbízható módon, egy mindenre kiterjedő öko tanúsítványt szerezzenek termékeikre. A vásárlók számára pedig ez egy újabb biztosíték arra, hogy végre nem kell átképezniük magukat kémikussá, és utánajárniuk az alapanyagoknak és az előállításuk folyamatának, hanem nyugodt szívvel leemelhetik a polcról az ilyen címkével ellátott termékeket. Az ökocímkéért felelős szakértőkkel, Kreiczinger Katalin ügyvezetővel és Fábián Attila okleveles vegyész tudományos munkatárssal beszélgettünk.

Ha UltraGreen tanúsítvánnyal rendelkező terméket szeretnénk, ezt a címkét kell keresnünk!
A piac tele van öko tanúsítványokkal. Hogy merült fel az igény az új ökocímkére?
Annak gondolata, hogy szükség lenne egy új tanúsításra már elég régen, 4-5 éve megfogalmazódott bennünk, mert az érintett hazai vállalkozások és vásárlók visszajelzési alapján nem volt – és most sincsen más – olyan tanúsítás, ami könnyen áttekinthető, következetes, nem az üzleti érdekek vezetik és reális költséggel elérhető. Számos hazai és külföldi innovatív vállalkozás van – és szerencsére egyre több – akik nem engedhetik meg maguknak a drága labor- és tanúsítási költségeket, emiatt hiába adott esetben korszerűbbek a termékeik mint a multi cégeké, hátránnyal indulnak a versenyben, kevesebb vásárlóhoz jutnak el ezeket a termékek, ami összességében a környezeti károk visszaszorítását is lassítja. Célunk a következő évben, hogy az UltraGreen tanúsítást a hazai gyártók és vásárlók szélesebb körével is megismertessük.
Az Önök cégében és magánéletében hogyan jelenik meg az öko szemlélet?
Magánszemélyként és vállalkozásként is mindannyian nagyon környezettudatosak vagyunk és igyekszünk élen járni a közlekedés (elektromos autó logisztika), újrahasznosítás és energia gazdálkodási (hamarosan a teljes energia igényünket napelemmel fogjuk fedezni) területeken is.
 A termékeknek szigorú vizsgálatokon kell megfelelniük, mielőtt kiérdemlik a címkét. A képek valódiak, nem illusztrációk!
A termékeknek szigorú vizsgálatokon kell megfelelniük, mielőtt kiérdemlik a címkét. A képek valódiak, nem illusztrációk!
Mitől különleges az UltraGreen ökocímke?
Az UltraGreen tisztítószer tanúsítvány a következőket garantálja:
1. Energiát spórol: az UltraGreen tisztítószerekből kis mennyiség is elegendő, általában koncentrátumok. Mosószerek esetén a címkével ellátott termékek 30°C-os mosási hőfokon is hatásosak.
Koncentrátum alatt általában az átlagos tenzid tartalom többszörösét szoktuk érteni. Az alacsony hőmérsékleten történő mosást enzimek használatával lehet megvalósítani.
Az UltraGreen Certification esetében - más tanúsításokkal együtt - más feltételek biztosítják ezeket a tulajdonságokat, például saját belső standard szerinti mosás hatékonyság vizsgálat (aminek az alapja lehet egy konkrét standard, például: 2017/1218 EU), hogy a "koncentrátum" és/vagy "alacsony hőmérsékleten is hatékonyan tisztít" marketing feltételek teljesüljenek. Máshogy nem lehet ezeket a feltételeket teljesíteni.
2. Az UltraGreen védi az egészséget és a környezetet: az egészségre és a környezetre ártalmas, vagy allergén anyagok egy részét tiltja, más részét korlátozza.
Fontos megkülönböztetni a kozmetikumokat és a tisztítószereket egymástól, mert egy alapanyagnak attól függően, hogy hol kell helytállnia más-más lehet a vele szemben támasztott követelmény.
Háztartásvegyipari termékek (tisztítószerek) esetében:
- Elektrolízissel előállított vegyületek (pl. NaOH).
- Nyílt térben égetéssel előállított vegyületek (pl. hamu).
Továbbá:
- Tartósítószerek, amik működésük során formaldehidre bomlanak.
- A parabén vegyület-családhoz tartozó tartósítószer molekulák és alapanyagok.
- Szuperabszorbens polimerek
- Egyéb szintetikus polimerek
- Alumíniumot tartalmazó szerves vagy szervetlen vegyületek
- Etilén-diamin-tetraecetsav és sói
- Foszfátok, foszfonátok, tripolifoszfátok
A konkrét vegyületek az erre a célra biztosított online adatbázisban ellenőrizhetőek is.
A termékeknek szigorú vizsgálatokon kell megfelelniük, mielőtt kiérdemlik a címkét. A képek valódiak, nem illusztrációk!
3. Nem károsítják az élővilágot: A környezetbe vagy vízbe jutás esetén nem károsítja az élővilágot, nem tartalmaz foszfátot, sem olyan fertőtlenítőszereket, amelyek hozzájárulhatnának a rezisztens baktériumok kifejlődéséhez.
Fontos tisztázni, hogy a leírtak a normál használat során vízbe került termékre vonatkoznak, tehát például mosás után távozó szürkevízről, amely a derítőbe, emésztőbe, kertbe, patakba, stb. távozik.
Természetesen ha bármilyen, akár teljesen természetes anyagból, például illóolajból vagy sóból töményen, nagy mennyiséget, mondjuk 2 tonnányit beleszórunk az édesvízű patakba, akkor minden ki fog pusztulni az adott területen (ha nem a szennyezés, akkor az oxigénhiány miatt). Ugyanakkor a címkével ellátott termékekből még ilyen esetben sem kumulálódik a természeti károsodás, vagyis nem hosszan tartó és visszafordíthatatlan, és nem terjed tovább, lokális marad. Ezért a kockázata az ilyen esemény bekövetkeztének elhanyagolható ellentétben más tisztítószerekkel, amik például olyan tartósítószert tartalmaznak, ami csak hosszútávon bomlik le.
4. Az UltraGreen csökkenti a műanyagszennyezést: az ilyen tanúsítvánnyal rendelkező tisztítószerek csomagolása újrahasznosítható, vagy biológiailag lebomló. A tisztítószer műanyag csomagolásának mennyisége (beleértve a gyűjtőcsomagolást is, amiben a boltokba érkezik) korlátozva van. A tisztítószer nem tartalmazhat mikroműanyagot.
A tanúsítvány az indokolatlan arányban felhasznált fosszilis műanyag csomagolásokat tiltja, amibe a gyűjtő csomagolás aránya is beletartozik, amit sok esetben a vevő nem is lát.
Tud újat mutatni az UltraGreen a többi ökocímkéhez képest?
Készült egy összehasonlító táblázat, amelyben az Ecolabel és az UltraGreen tanúsítványt hasonlítjuk össze:
| UltraGreen | EU Ecolabel | |
| Hatékonyság tesztelése | A tisztítószerek hatékonyságát a tanúsító szerv saját laborjában, a 2017/1218 EU standard követelményeinek megfelelően vizsgálják. | A tisztítószerek hatékonyságát a 2017/1218 EU standard követelményeinek megfelelően vizsgálják. |
| A csomagolás hatásmutatójának (Impact Ratio) vizsgálata | igen ✓ | igen ✓ |
| A triklozán, parabének, formaldehid, és a formaldehidre bomló anyagok tilalma | igen ✓ | igen ✓ |
| Elektrolízissel előállított vegyületek (pl. NaOH, KOH) tiltása | igen ✓ | nem X |
|
Szintetikus polimerek (pl. karbomerek, akril polimerek) tiltása |
igen ✓ | nem X |
Mi a gond a nátrium-hidroxiddal, kálium-hidroxiddal? Ezeket az anyagokat régóta használjuk szappankészítéshez például.
Ennek a tiltásnak az oka a NaOH és KOH előállítása során keletkező Cl2 gáz melléktermék, amit kényszerűen a PVC előállítására kell használni. Ebből az is következik, hogy jelenleg a most legnépszerűbb öko mosószerek többsége nem felel meg ennek a követeleménynek, mert általában valamilyen káliszappant tartalmaznak.
Fontos megjegyezni, hogy a fentiek a jelenlegi szabályokat tükrözik, amiket az új tudományos ismeretek és fejlesztések fényében folyamatosan felülvizsgálunk!

A termékeknek szigorú vizsgálatokon kell megfelelniük, mielőtt kiérdemlik a címkét. A képek valódiak, nem illusztrációk!
Hogyan kell elképzelni a tisztítószer tanúsításához használt eljárást?
Az OECD 301B egy tesztsorozat, ahol vizsgálják az aerob vizi környezetben történő biológiai lebonthatóságát az adott alapanyagoknak és/vagy konkrét tisztítószernek, amiből következtetni lehet az adott minta környezeti viselkedésére. Minél rövidebb idő alatt képesek a mikroorganizmusok lebontani az adott vegyület(eket), annál kisebb a környezetre gyakorolt negatív hatása. Természetesen ezt nem szabad összekeverni más negatív hatásokkal pl. eutrofizációval (vízvirágzás, nagy mennyiségű foszfor vízbe kerülése esetén extrém módon túlszaporodnak bizonyos algák, ami a víz oxigéntartalmának csökkenéséhez, ez pedig halpusztuláshoz vezet), aminek a kiküszöbölését más követelmények biztosítanak pl. foszfátok, foszfonátok, tripolifoszfátok mentesség.
Igen, az UltraGreen Certificate-al rendelkező termékek nem jelentenek környezeti kockázatot a szürkevíz felhasználása során normál felhasználás mellett.
Tervezik-e esetleg tovább szigorítani a követelményrendszert?
Igen, ahogy új felfedezések születnek, és ahogy a tudományos ismeretek is egyre gyarapodnak, ezeknek megfelelően folyamatosan felülvizsgáljuk a követelményrendszert.
Az UltraGreen tanúsítvánnyal rendelkező tisztítószereket ITT TALÁLJÁTOK a Zöldbolt kínálatában.
További részletek az ökocímkével kapcsolatban itt találhatóak: https://ultragreencert.com/detergents
Az UltraGreen tanúsítvánnyal kozmetikumokat is tanúsítanak, ott még szigorúbbak a követelmények. Erről itt olvasható több információ: https://ultragreencert.com/cosmetics


